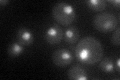
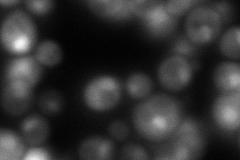
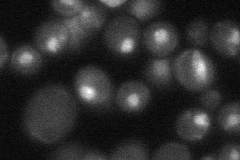

View description
Subunit of the RNA polymerase II mediator complex; associates with core polymerase subunits to form the RNA polymerase II holoenzyme; essential for transcriptional regulation
Localization:
Intensity:
Fold change:
Significance:
-
C’ GFP library in SD
nucleus35.86 -
N' NOP1pr-GFP in SD

cytosol,nucleus68.4491 -
N' TEF2pr-mCherry in SD
cytosol,nucleus7.8477 -
N' NATIVEpr-GFP in SD
punctate,nucleus32.4618 -
N' TEF2pr-VC and Cyto-VN in SD

nucleus37.7578 -
C’ GFP library in SD+DTT

nucleus37.551.04No -
C’ GFP library in SD+H2O2

nucleus44.391.23No -
C’ GFP library in Starvation Media

nucleus36.061No -
C’ GFP library on the background of Pup2-DaMP

nucleus -
C’ GFP library on the background of CCT mutant

nucleus32.58750.908624No
